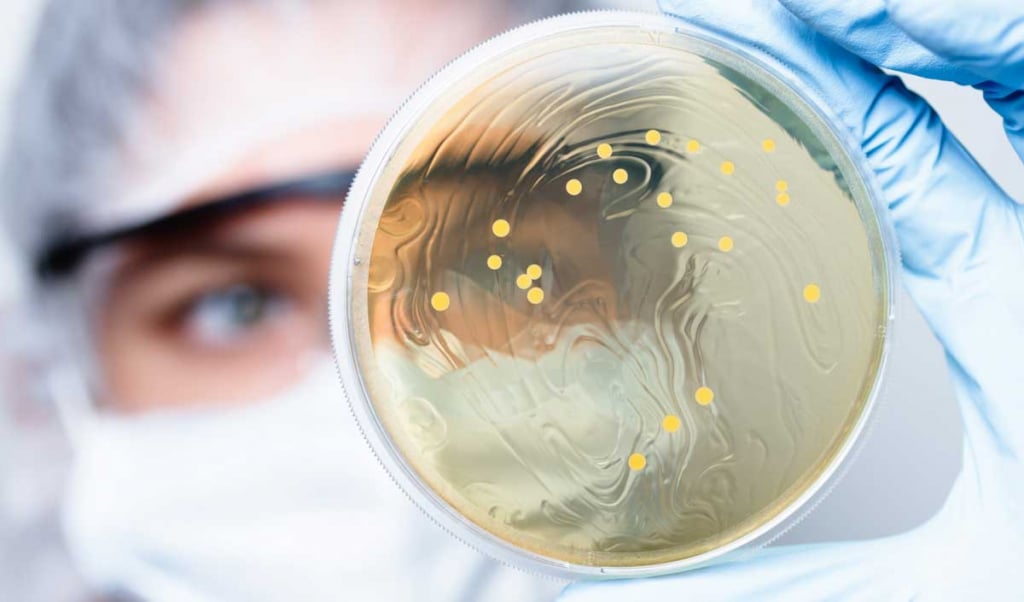
Les touristes rapportent des bactéries intestinales multirésistantes de pays lointains

La résistance aux antibiotiques est très répandue dans les pays ou l’utilisation de ces médicaments est insuffisamment contrôlée. Les voyages ou déplacements internationaux contribuent largement à la propagation de ces bactéries qui diminuent ou annulent les effets des antibiotiques. Ce phénomène existe à l’échelle mondiale et l’antibiorésistance est devenu un problème de santé publique.
Propagation des bactéries résistantes lors des voyages
Des centaines de millions de visiteurs qui se rendent dans des destinations étrangères et lointaines sont exposés à des bactéries intestinales gram-négatives multirésistantes et 30 à 70 % des voyageurs présentent une colonisation de ces micro-organismes dans leur organisme lors et après leur séjour.
Jusqu’à présent, le processus de colonisation dans les zones exposées à ce phénomène était peu documenté car les données nécessaires sur la composition du microbiome n’avaient été collectées qu’une fois avant le voyage puis au retour.
La présente étude est la première à analyser sur des touristes volontaires la dynamique précise de la colonisation par des germes multirésistants. Pour ce faire, ils ont prélevé des échantillons de selles chez ces voyageurs avant le départ puis tous les jours pendant le voyage (sur une durée de 22 jours) et enfin, au retour. Ainsi, les scientifiques ont rassemblé des données sur le processus d’acquisition de ces bactéries intestinales multirésistantes. Les volontaires avaient également un carnet de bord afin d’y noter leurs habitudes alimentaires, la prise de médicaments et les troubles gastro-intestinaux si ces derniers apparaissaient.
Les points forts de cette étude
- En plus de révéler le phénomène de l’antibiorésistance à l’étranger, le nombre étonnamment élevé de souches multirésistantes qui ont été identifiées indique un risque beaucoup plus important pour les voyageurs qu’on ne le pensait auparavant.
- Les bêta-lactamases à spectre étendu ou élargi (BLSE) sont des enzymes produites par des bactéries intestinales à Gram négatif telles qu’Escherichia coli et Klebsiella, qui désactivent certaines classes d’antibiotiques importantes telles que la pénicilline, la céphalosporine et le monobactame.
- Les gènes des BLSE se trouvent dans des plasmides (fragment d’ADN de bactéries) qui peuvent être transférés entre bactéries de la même espèce.
- Les 20 participants à l’étude ont tous eu, à un moment ou à un autre, des bactéries porteuses de gènes BLSE.
- À leur retour en Europe, 70 % des vacanciers étaient encore positifs aux BLSE.
Conclusion
L’étude souligne la nécessité de prévenir la diarrhée du voyageur par la prise de probiotiques spécifiques et de réduire de manière générale l’utilisation d’antibiotiques afin de minimiser le développement de l’antibiorésistance et sa transmission à d’autres personnes.












































